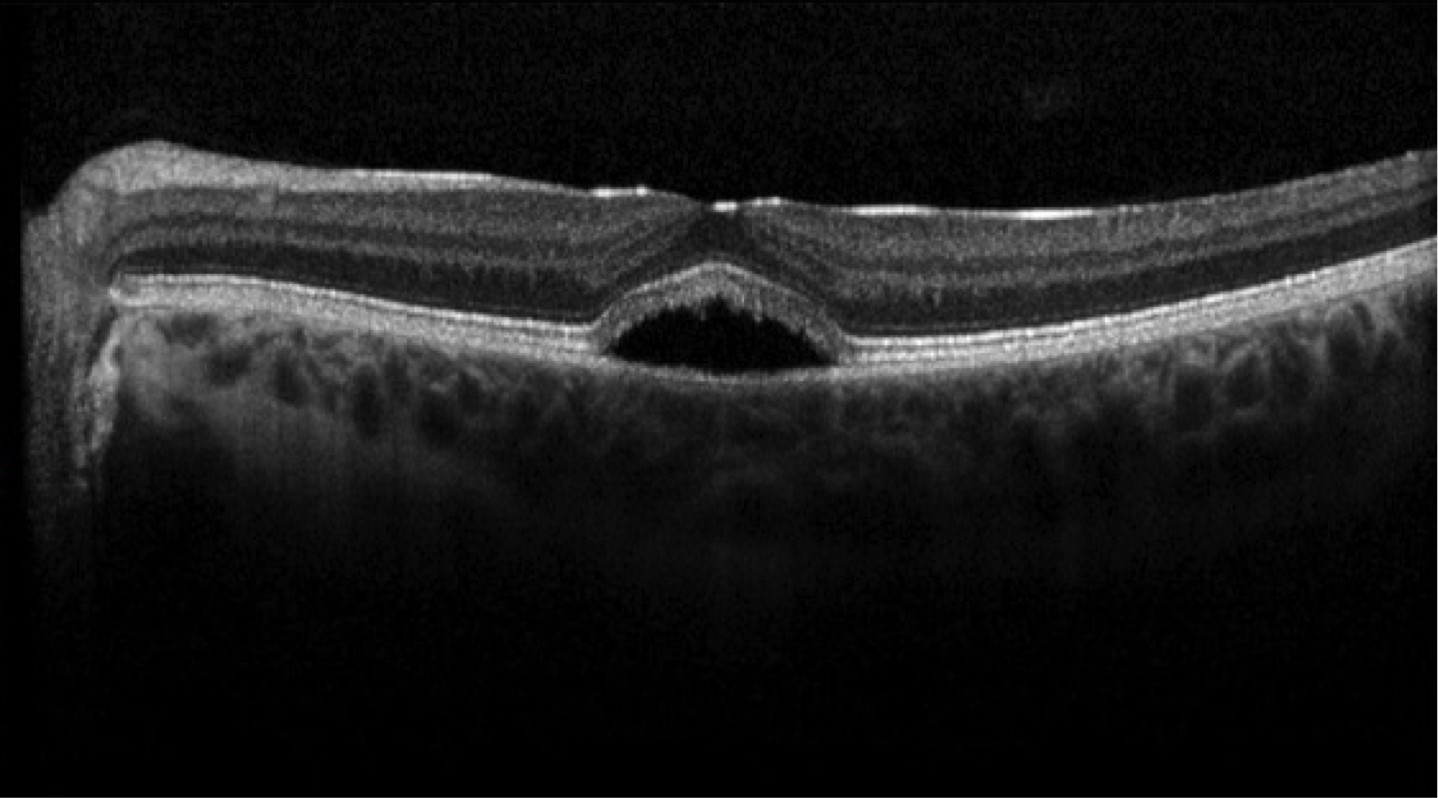

Big 14 Self-Assessment
Case 4
Case 4 is a 17 year old male who has normal night vision, normal peripheral vision and 20/20 central acuity. He has a family history of adult onset loss of visual acuity in his mother and a number of his maternal relatives.